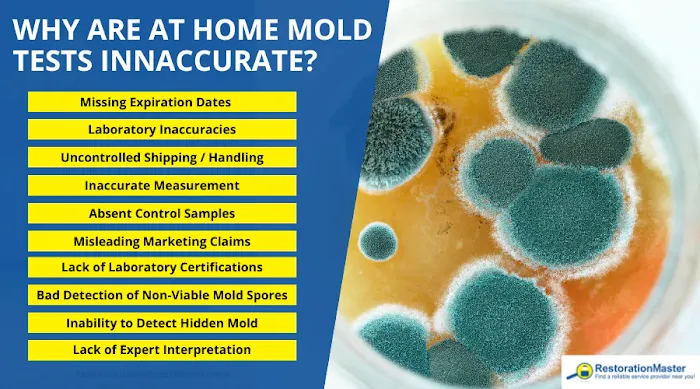
RestorationMaster Picture 5

RestorationMaster Photos

RestorationMaster Introduce
Welcome to the essential guide for property owners in the greater St. Petersburg, Florida, area. Living in the Sunshine State, we often face unique challenges, from sudden storm damage to unexpected plumbing issues that lead to water and mold problems. When disaster strikes, you need more than just a cleanup crew; you need a full-service partner who can manage the entire process, from emergency mitigation to complete reconstruction. This is where a professional and experienced general contractor specializing in disaster restoration makes all the difference.
RestorationMaster stands as a premier provider in Pinellas County, offering comprehensive disaster restoration and general contracting services designed to bring your property back to its pre-loss condition, or even better. Our commitment is to offer peace of mind during highly stressful times by delivering professional, compassionate, and efficient service. Our team is equipped, trained, and ready to handle the full scope of your property damage, ensuring a seamless transition from initial cleanup to final rebuild. We understand the complex nature of property damage and the critical role a licensed general contractor plays in coordinating every step of the restoration process.
We serve both residential and commercial clients across St. Petersburg, ensuring that whether it is your family home or your business operations that have been disrupted, you receive the same high level of dedicated care and expertise.
Location and Accessibility
Conveniently situated to service St. Petersburg, Pinellas County, and the surrounding regions, RestorationMaster is strategically located to provide fast, emergency response services when you need them most. In a disaster situation, every minute counts, which is why local accessibility is crucial for minimizing damage and reducing restoration time.
Our primary operating location ensures we can dispatch crews quickly for water damage restoration, fire cleanup, and storm damage repair across the city and neighboring communities. Our focus on local service means a deep understanding of Florida’s specific building codes, permitting processes, and common regional property issues like severe storm impact and mold growth due to high humidity.
For those needing to visit or coordinate onsite services, the facility is designed with client needs in mind. Accessibility features include a wheelchair-accessible entrance and a wheelchair-accessible parking lot, ensuring that all customers can comfortably access consultation and support services.
Services Offered
As a full-service general contractor specializing in property damage, RestorationMaster provides a comprehensive range of solutions. Our expertise covers the emergency cleanup and restoration phase, the necessary repairs, and the complete building reconstruction required after a major loss. We act as your single point of contact to coordinate all necessary trades and services, alleviating the stress of managing multiple contractors.
Our wide array of services includes:
UL
LI Water Damage Restoration Service
UL
LI Water Extraction and Dehumidification
LI Flood Cleanup and Flood Restoration
LI Broken Pipes Cleaning and Aftermath Cleanup
LI Structural Damage Assessment and Building Stabilization
LI Emergency Disaster Restoration and Disaster Mitigation
UL
LI Fire Damage Restoration Service
UL
LI Fire Cleanup and Soot and Smoke Damage removal
LI Smoke Damage Restoration Services and Smoke Removal
LI Content Cleaning and Pack-Out Services
UL
LI Mold Remediation Services
UL
LI Mold Damage Restoration and Mold Mitigation
LI Mold Removal / Mold Remediation and Mold Cleaning
LI Environmental Testing Service
UL
LI General Contracting and Building Restoration Service
UL
LI Full Reconstruction Services and Repair Services
LI Complete Home Remodeling and Home Restoration
LI Siding, Roofing, and other exterior repairs
LI Air Duct Cleaning Services
LI Post-Construction Cleaning
UL
LI Storm and Wind Damage Cleanup and Restoration
UL
LI Storm Damage Restoration for Storm or Flood incidents
LI Tree Care services in connection with storm damage
UL
LI Specialty and Cleaning Services
UL
LI Biohazard Cleanup, Trauma Scene Cleaning Services, and Suicide Cleanup Services
LI Hoarding Cleaning Services and Hoarding Cleanup
LI Commercial Cleaning and Residential Cleaning
LI Carpet Cleaning and Furniture Restoration
LI Disinfection Services and Restoration Disinfection
LI Property Maintenance
UL
Features / Highlights
Choosing a contractor, especially in a time of crisis, requires trust and confidence in their capabilities. RestorationMaster offers several key features and highlights that set them apart in the Florida restoration and general contracting market:
UL
LI Full-Service General Contracting: We are not just a cleanup company. Our scope of work includes General Contracting, allowing us to manage every aspect of the rebuild process. This means seamless project flow from cleanup through to final reconstruction and remodeling, eliminating the need for you to hire and coordinate multiple different companies.
LI 24/7 Emergency Response: Disasters don't adhere to business hours. RestorationMaster offers immediate, round-the-clock emergency disaster restoration services. This rapid response capability is vital for mitigating further damage, particularly with water and fire losses. As one satisfied customer noted, their call was "taken quickly" and the crew arrived promptly.
LI Comprehensive Disaster Expertise: Our team is trained and experienced in all major categories of property damage that frequently affect Florida homes and businesses: water, fire, smoke, storm, and mold. We bring extensive expertise to handle the complexities unique to Florida's climate and environment.
LI Client-Focused, Compassionate Service: Customers consistently praise the professionalism, patience, and genuine concern shown by our crews. They take the time to explain the process, reducing client stress during emotionally difficult times. One review highlighted, "The professionalism and dedication the crew showed me, my family and our home was outstanding."
LI Integrated Reconstruction Capabilities: Beyond mitigation, we have the in-house capabilities to handle major structural repairs, home remodeling, and complete home and building restoration, ensuring a consistent quality standard from start to finish.
LI A Single Point of Contact: By serving as the general contractor, we coordinate all necessary sub-trades, permits, and planning, providing the customer with one primary contact for all questions and updates, simplifying a complex process.
LI Onsite Services: The availability of onsite services means our team is ready to meet with you at your property to assess the damage and begin work immediately, providing highly responsive service right where it is needed.
UL
Contact Information
For emergency restoration and general contracting services in the St. Petersburg, Florida, area, you can reach RestorationMaster using the contact information below.
Address: 970 Lake Carillon Dr #300, St. Petersburg, FL 33716, USA
Phone (Emergency and Office): (813) 730-4258
Mobile Phone: +1 813-730-4258
What is Worth Choosing
Choosing RestorationMaster is choosing a partner that provides a crucial, end-to-end solution for property owners in the St. Petersburg and greater Florida region. In the face of a crisis—a flooded basement from broken pipes, the devastation of a fire, or the structural threat posed by a severe storm—the ability to act fast and follow through with expert construction is paramount.
What truly sets this firm apart is the combination of specialized disaster restoration skills with the licensure and capability of a full general contractor. This dual expertise means you are protected from the moment the initial damage occurs to the final coat of paint on your rebuilt property. The team will not only perform the initial water removal, drying, and sanitization but will also manage the entire 'Rebuild and Restore' phase, including all structural repairs, remodeling, and necessary renovations. The process is streamlined, minimizing delays often caused by transitioning between a mitigation company and a separate general contractor.
As one homeowner shared, the team "took away so much stress" after a flood. This is the core value proposition: providing compassionate service and taking ownership of the full property recovery. For any Florida homeowner or business facing property damage, RestorationMaster offers a dedicated, professional, and comprehensive service that is "more than a 5 star service," ensuring your property and peace of mind are fully restored.
In conclusion, for residents and business owners across St. Petersburg and Pinellas County, navigating property damage requires an experienced hand. RestorationMaster’s commitment to rapid emergency response, comprehensive service offerings—from mold remediation to complete reconstruction—and a consistently praised customer-first approach make them the clear choice for professional disaster restoration and general contracting needs. When trouble hits, and you need reliable, dedicated, and skilled professionals, knowing you have a partner who handles all phases of the project, from contamination and removal to final renovation, is an invaluable asset.
RestorationMaster Services
Water Damage Restoration Service
- Carpet cleaning
- Flood cleanup
- Flood restoration
- Mold cleaning
- Mold damage restoration
- Mold mitigation
- Mold remediation
- Water removal
- Aftermath Cleanup
- Biohazard Cleanup
We provide biohazard and trauma scene cleaning services in St. Petersburg, FL to remove biohazard materials and restore the scene to a safe condition.
- Building Stabilization
- Clean And Restore
- Commercial Cleaning
- Commercial Cleaning Services
- Construction Services
- Contamination And Remove
- Content Cleaning And Pack Out
- Content cleaning
We provide complete content cleaning and pack-out services in St. Petersburg, FL to ensure that your damaged personal items are fully cleaned and restored back to their original condition. The cleaning will be done on-site unless your home is unstable.
- Disaster Mitigation
- Disaster Restoration And Cleaning Services
- Disinfection Services
- Emergency Disaster Restoration
- Emergency Disaster Restoration Services
- Environmental Testing
- Environmental Testing Service
- Fire Damage Restoration
- Flood Damage Restoration
- Furniture Restoration
- General Contracting
- Hoarding Cleaning Services
- Hoarding Cleanup
We provide hoarding cleaning services in St. Petersburg, FL to clean and restore the homes of hoarders to sanitary living conditions. We understand that hoarding is a sensitive issue and we approach the individual with respect and compassion.
- Hoarding Cleanup Services
- Home Remodeling
- Home Restoration
- Maid Services
- Medical Waste Disposal
- Mold Remediation Services
- Mold Removal And Mold Remediation
- Property Damage
- Property Maintenance
- Rebuild And Restore
- Repair Services
- Residential Cleaning
- Restoration Disinfection
- Scene Cleaning Services
- Siding, Roofing
- Smoke Damage Restoration Services
- Soot And Smoke Damage
- Storm Damage
- Storm Damage Restoration
- Storm Or Flood
- Storm and Wind Damage Cleanup
We provide quick and efficient wind and storm damage restoration services in St Petersburg, FL. We have the knowledge, equipment, expertise, and the resources to tackle this job in an efficient manner. We can help you if your home suffers from a hurricane or tornado.
- Structural Damage
- Suicide Cleanup Services
- Trauma Scene Cleaning Services
- Tree Care
- Water Extraction And Dehumidification
- Water Restoration
We provide water damage restoration services to extract water and moisture from your property in St. Petersburg, FL and repair the structural damage. We use advanced drying and extraction equipment to stop the water from spreading and ensure that all excess water and moisture is completely removed.
- broken pipes cleaning
- fire cleanup
We provide fire damage restoration services in St. Petersburg, FL to help damaged homes and businesses recover after a fire. We can clean up soot and smoke damage with our advanced cleaning equipment and products as well as repair structural damage.
- flooded basement cleaning
We provide flood damage cleanup services in St. Petersburg, FL to clean up and restore homes and businesses affected by flooding. We use advanced water extraction and dehumidification equipment to completely remove the flood water and thoroughly dry the affected surfaces and materials.
- mold removal / mold remediation
We provide mold remediation services in St. Petersburg, FL to help contain the contamination and remove mold from a space of 10 square feet or less. If the mold affects a larger area of your home or building, we will recommend an environmental testing service to test your home.
- post construction cleaning
- smoke removal
- trauma scene cleaning
Building Restoration Service
- Air Duct Cleaning Services
- Reconstruction Services
RestorationMaster Details
Service options
- Onsite services
Accessibility
- Wheelchair accessible entrance
- Wheelchair accessible parking lot
RestorationMaster Location
RestorationMaster
970 Lake Carillon Dr #300, St. Petersburg, FL 33716, USA
RestorationMaster Reviews
As a homeowner we all find ourselves in need with help after Mother Nature takes her toll on us all in Florida. Trying to recover from a flood is hard but Service Master took away so much stress. The professionalism and dedication the crew showed me, my family and our home was outstanding. Yes it was their job but they were very patient with me and explained everything. If you find yourself in need (like I did) give them a call. Thank you Mike for all of your help.
Feb 20, 2024 · Michelle GarlickWhen I called Restoration Master Water & Fire Damage, my call was taken quickly and they were genuinely concerned about me and my safety and my property. They sent crews over, who were professional and caring. The problem was resolved in days and I could not be happier. When trouble hits you need to call Restoration Master Water & Fire Damage! They are more than a 5 star service!
Feb 22, 2024 · j ConnWe had catastrophic mold damage and ServiceMaster Disaster Relief really helped us out. They were on site almost immediately and began remediation process. They walked us through each step and answered all our questions. Awesome job. Thanks Mike, Andre, Mike and Gary !
Feb 21, 2024 · William StricklerWorking with RestorationMaster is a seamless and efficient process. The quality of their work and performance is exceptional. Their customer service is outstanding. Good business to business service.
Feb 20, 2024 · Nino EtienneThanks for your quick response. We appreciate you explaining the mitigation process to help us understand what we should expect from start to finish. We would recommend choosing your company for sure!
Feb 21, 2024 · Tonya Howell
More Water Damage Restoration Near Me
 United Water Restoration Group of Pinellas County4.0 (124 reviews)
United Water Restoration Group of Pinellas County4.0 (124 reviews)3734 131st Ave N Ste 12, Clearwater, FL 33762, USA
 Water Restoration Pros5.0 (2 reviews)
Water Restoration Pros5.0 (2 reviews)3223 62nd Ave N Unit C, St. Petersburg, FL 33702, USA
 Roto-Rooter Plumbing & Water Cleanup4.0 (2095 reviews)
Roto-Rooter Plumbing & Water Cleanup4.0 (2095 reviews)5052 Haines Rd N, St. Petersburg, FL 33714, USA
 Restoration Kings5.0 (7 reviews)
Restoration Kings5.0 (7 reviews)5001 49th St N Suite B, St. Petersburg, FL 33709, USA
 PuroClean of Downtown St. Petersburg5.0 (50 reviews)
PuroClean of Downtown St. Petersburg5.0 (50 reviews)3135 39th Ave N, St. Petersburg, FL 33714, USA
 Legacy Restoration LLC4.0 (10 reviews)
Legacy Restoration LLC4.0 (10 reviews)3284 Morris St N, St. Petersburg, FL 33713, USA
 PuroClean of Pinellas Park4.0 (32 reviews)
PuroClean of Pinellas Park4.0 (32 reviews)6577 49th Ave N, Kenneth City, FL 33709, USA
 Certified Mold & Water Damage Restoration Team LLC5.0 (115 reviews)
Certified Mold & Water Damage Restoration Team LLC5.0 (115 reviews)467 7th Ave N Unit 403, St. Petersburg, FL 33701, USA
 Pure Water Restoration of Downtown St. Petersburg0.0 (0 reviews)
Pure Water Restoration of Downtown St. Petersburg0.0 (0 reviews)111 2nd Ave NE, St. Petersburg, FL 33701, USA
 Flood Pros USA4.0 (33 reviews)
Flood Pros USA4.0 (33 reviews)100 2nd Ave NE Suite 240-01, St. Petersburg, FL 33701, USA
 Rapids Flood Team5.0 (66 reviews)
Rapids Flood Team5.0 (66 reviews)200 Central Ave 4th Floor, St. Petersburg, FL 33701, USA
 Dry Rely Water Damage Restoration5.0 (3 reviews)
Dry Rely Water Damage Restoration5.0 (3 reviews)300 10th St S ste 840, St. Petersburg, FL 33705, USA
Categories
Top Visited Sites
 AAA Dry Foam Professional Cleaning, Inc.5.0 (5 reviews)
AAA Dry Foam Professional Cleaning, Inc.5.0 (5 reviews) Davis Drain Cleaning4.0 (80 reviews)
Davis Drain Cleaning4.0 (80 reviews) Consolidated Construction Services4.0 (66 reviews)
Consolidated Construction Services4.0 (66 reviews) Aqua Fast Water Damage Clean up and Mold Remediation0.0 (0 reviews)
Aqua Fast Water Damage Clean up and Mold Remediation0.0 (0 reviews) Good Guy Home Improvements, LLC5.0 (76 reviews)
Good Guy Home Improvements, LLC5.0 (76 reviews) Roto-Rooter Sandusky Plumbing & Drain Services4.0 (727 reviews)
Roto-Rooter Sandusky Plumbing & Drain Services4.0 (727 reviews)Top Water Damage Restoration Searches
Trending Damage Repair Guides Posts
 Water Damage Repair for Hardwood Stairs Made Simple
Water Damage Repair for Hardwood Stairs Made Simple How to Repair Water Damage for Tile and Grout: A Complete Guide
How to Repair Water Damage for Tile and Grout: A Complete Guide How to Minimize Water Damage in Your Home During Winter - Expert Tips and Advice
How to Minimize Water Damage in Your Home During Winter - Expert Tips and Advice Water Damage Repair for Attics and Roof Spaces
Water Damage Repair for Attics and Roof Spaces The Dangers of Untreated Water Damage in Your Home
The Dangers of Untreated Water Damage in Your Home How to Prevent Water Damage in Your Home’s Crawl Space and Basement
How to Prevent Water Damage in Your Home’s Crawl Space and Basement
